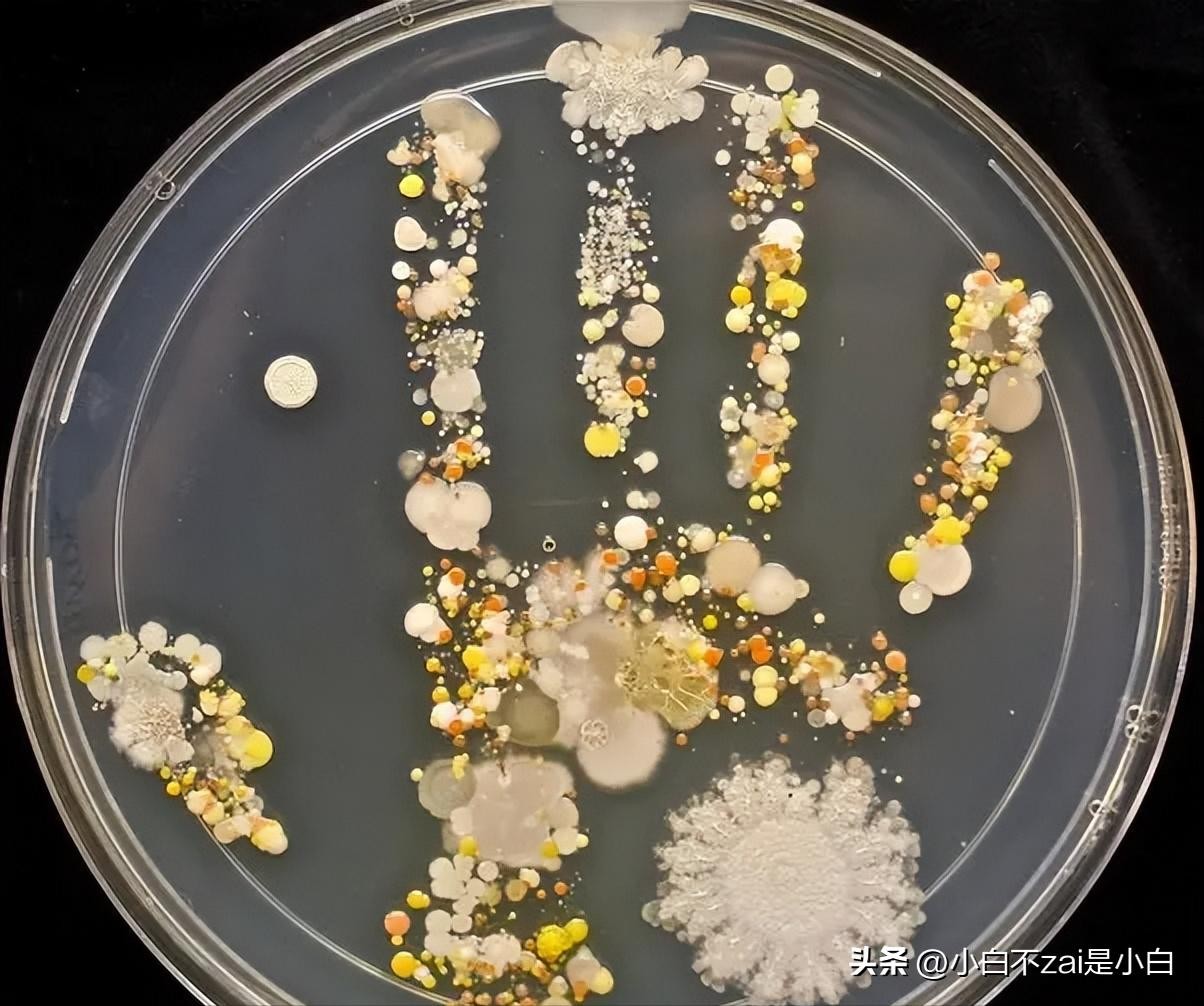

43张--诡异至极的照片,惊悚的让你尖叫!
43张--诡异至极的照片,惊悚的让你尖叫!
看上去,这是什么?我什么都不说,自己看
4、一个长期吃“生鱼片”的能人,ct下他的肺长满寄生虫,让人头皮发麻

5、晒干的黄釣鱼干,还以为看到了外星人

6、黑暗,空无一人的走廊,什么都没有,但是好像总有什么

7、一条被食舌虱寄生的鱼,令人发毛,这种寄生虫会吃掉鱼的舌头,然后寄生在喉咙处

8、四只脚的鸡,见过吗?

9、因为疫情,一对新人教堂结婚,都没有宾客到场只能贴满照片,本来温馨的婚礼现场,总感觉有点诡异

10、法国一种古老残忍的美食:烤圃鸡,法国人捕捉到之后,会用针刺瞎眼睛,然后不断喂食,然后再用酒灌醉之后再烤了吃

11、奇怪的房子,可以反转

12、古罗马苦行僧,在钉子上睡觉

13、你以为是向日葵,其实是一个蜂巢

14、一直被钢筋折磨而死的海龟,看得出来临死前是多么难受

15、1000倍显微镜下眼睫毛,密集恐惧的不要看

16、一个8岁小朋友的手掌,上面有多少细菌,看
17、仔细看,一条双头蛇,还是眼镜蛇,神器不?蛇年大吉

18、放大1000倍的头皮头发,不知道为什么看上去还有点葱头

19、来大家看看,冠军在这里

20、是不是感觉这个女的表情很怪异,其实很简单,这是这位女士在弥留之际,死前的最后一张照片

21、街边在繁茂的树枝后面的一盏路灯,这个角度看过去,有点恐怖

22、古巨龟,几亿年前的生物,果然那是一个很难想象的世界

23、制作塑料模特的工厂流水线,不过说实话,眨眼一看,还是挺诡异的

24、亚马逊丛林里的一棵树,看看树上长出来的树结,你们说像什么

25、晚上醒来,如果发现你家小宠物这么看着你,是不是有点吓人,这种表情

26、一颗不知道从哪里飘过来的红气球,静静地飘着,好像有人牵着走一样

27、日本街头,一群人都在认真听着,但是有一个女的突然这么诡异的歪头,有没有一种山村老尸走进现实的感觉

28、位于印度的科利山路,仅仅10多公里的路程,竟然有70个弯道,难怪这条路还有一个别称“死亡之山”。

29、喜玛拉雅猴花,据说每20年才开花一次。就说猴子来了都得叫声“孩儿们”

30、上世纪60年代,位于夏威夷的火山在海底喷发,流出来的熔岩像是一个圆形的红色喷泉,高达70米。

31、二战结束的时候,坐车轮船返家的美国人,真担心船被他们压沉没了!

32、泛黄的老照片里可不一定都满是温馨,很有可能也藏着几个天雷。下面这些老照片就很是不普通,衣服怪异、动作怪异,连长相也透着一股怪异,古人看来很喜欢拍雷人雷事。

33、看看这一家子

34、在危地马拉城,一个巨大的天坑突然出现,它像一个无尽的黑洞,吞噬着周围的一切,让人不寒而栗

35、一个软木盖活板门下隐藏着蜘蛛的陷阱,它看起来像一枚古钱币,但实际上却隐藏着致命的危险。

36、一张9000年前的石头面具,引人无限遐想。

37、“为了躲避洪水,这些臭虫聚集在这根水泥柱的顶端。”尽管很多人表示这张图片超出了自己的心理承受极限,但这绝对是关于地狱的绝佳素材...

38、这块大石头给人一种阳刚的感觉,大自然果然是鬼斧神工!
39、这位名为艾珀的女士患有一种奇特的关节疾病,后来她便在马戏团中找到了工作。

40、这个小女孩原本是双胞胎之一,她的妹妹已经过世,她身后就是她妹妹的坟墓。

42、先看一下这个女人,再仔细看一下女人的脚,有没有发现脚和身体并没有连着,身体是架空的,并且眼睛上翻…其实 这个女人已经死了。这是一张冥婚图片……看过的人会…

43、自从有了拖网渔船,海底的各路怪物就常常被捞起来。一条可怕的蠕虫,似乎还能看到它头上的清晰五官,和多少有些诡异的表情…

#爆料##头条猜猜看##赵露 思##怪物##网红##诡异##鬼##奇怪##满怀信心 埋头实干#